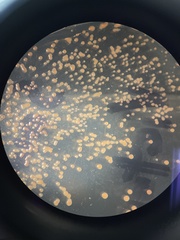
Saccharomyces cerevisiae

©Safron, some rights reserved (CC-BY-NC)
©Safron, some rights reserved (CC-BY-NC)
©Safron, some rights reserved (CC-BY-NC)
©Safron, some rights reserved (CC-BY-NC)
©Safron, some rights reserved (CC-BY-NC)
©Safron, some rights reserved (CC-BY-NC)
©natthawut, some rights reserved (CC-BY-NC)
©craftyfollow, some rights reserved (CC-BY-NC)
©craftyfollow, some rights reserved (CC-BY-NC)
©craftyfollow, some rights reserved (CC-BY-NC)
©craftyfollow, some rights reserved (CC-BY-NC)
©craftyfollow, some rights reserved (CC-BY-NC)
©craftyfollow, some rights reserved (CC-BY-NC)
©craftyfollow, some rights reserved (CC-BY-NC)
©craftyfollow, some rights reserved (CC-BY-NC)
©craftyfollow, some rights reserved (CC-BY-NC)
©craftyfollow, some rights reserved (CC-BY-NC)
©Cristiane Colodel, some rights reserved (CC-BY-NC-ND)
©Cristiane Colodel, some rights reserved (CC-BY-NC-ND)
©jzlloyd, some rights reserved (CC-BY-NC)
©jzlloyd, some rights reserved (CC-BY-NC)
©jzlloyd, some rights reserved (CC-BY-NC)
©David Renoult, some rights reserved (CC-BY-NC)
©keithandmarchant, some rights reserved (CC-BY-NC)
©keithandmarchant, some rights reserved (CC-BY-NC)
©Charcos Companhia, some rights reserved (CC-BY-NC)
©Charcos Companhia, some rights reserved (CC-BY-NC)
©Kiloueka, some rights reserved (CC-BY-NC)
©Kiloueka, some rights reserved (CC-BY-NC)
©cavaloca, some rights reserved (CC-BY-NC)
©cavaloca, some rights reserved (CC-BY-NC)
©cavaloca, some rights reserved (CC-BY-NC)
©cavaloca, some rights reserved (CC-BY-NC)
©Beah Vega, some rights reserved (CC-BY)
©Beah Vega, some rights reserved (CC-BY)
©Austin 0201, some rights reserved (CC-BY)
©Rob Norris, some rights reserved (CC0)
©Rob Norris, some rights reserved (CC0)
©maddy_w, some rights reserved (CC-BY-NC)
©maddy_w, some rights reserved (CC-BY-NC)
©agosti, some rights reserved (CC0)
©jordanmcarlin, some rights reserved (CC-BY-NC)
©jordanmcarlin, some rights reserved (CC-BY-NC)
©angelamamari, some rights reserved (CC-BY-NC)
©le_biologiste, some rights reserved (CC-BY-NC)
©jacrosand, some rights reserved (CC-BY-NC)
©jsikkema631, some rights reserved (CC-BY-NC)
©garagel-acari, some rights reserved (CC-BY-NC)
©garagel-acari, some rights reserved (CC-BY-NC)
©garagel-acari, some rights reserved (CC-BY-NC)
©morganinn, some rights reserved (CC-BY-NC)
©morganinn, some rights reserved (CC-BY-NC)
©vadi3007, some rights reserved (CC-BY-NC)
©Alan Rockefeller, some rights reserved (CC-BY)
©Alan Rockefeller, some rights reserved (CC-BY)
©Alan Rockefeller, some rights reserved (CC-BY)
©Chris Combs, some rights reserved (CC-BY-NC)
©edvega2, some rights reserved (CC-BY-NC)
©Bobby McCabe, some rights reserved (CC-BY)
©miyachinn, some rights reserved (CC-BY-NC)
©Cristian Riquelme, some rights reserved (CC-BY)
©Cristian Riquelme, some rights reserved (CC-BY)
©Cristian Riquelme, some rights reserved (CC-BY)
©Ann Schunior, some rights reserved (CC-BY-NC)
©Suzanne Mrozak, some rights reserved (CC-BY-NC)
©Ezequiel Vera, some rights reserved (CC-BY-NC)
©rebeccayoung98, some rights reserved (CC-BY-NC)
©sigillaria, some rights reserved (CC-BY-NC)
©clem, some rights reserved (CC-BY-NC)
©ericag0112, some rights reserved (CC-BY-NC)
©ericag0112, some rights reserved (CC-BY-NC)
©ericag0112, some rights reserved (CC-BY-NC)
©ericag0112, some rights reserved (CC-BY-NC)
©ericag0112, some rights reserved (CC-BY-NC)
©ericag0112, some rights reserved (CC-BY-NC)
©ericag0112, some rights reserved (CC-BY-NC)
©ericag0112, some rights reserved (CC-BY-NC)
©rzickerman, some rights reserved (CC-BY-NC)
©leahtoomey, some rights reserved (CC-BY-NC)
©adebisiadetoye, some rights reserved (CC-BY-NC)
©cdebahbio, some rights reserved (CC-BY-NC)
©Kaela Roy, some rights reserved (CC-BY-NC)
©Kaela Roy, some rights reserved (CC-BY-NC)
©Kaela Roy, some rights reserved (CC-BY-NC)
©Kaela Roy, some rights reserved (CC-BY-NC)
©daniyang, some rights reserved (CC-BY-NC)
©skather94, some rights reserved (CC-BY-NC)
©Larry Chen, some rights reserved (CC-BY-NC)
©dtrinter, some rights reserved (CC-BY-NC)
©akilaganapathi, some rights reserved (CC-BY-NC)
©Valentina, some rights reserved (CC-BY-NC)
©Philip Freeman, some rights reserved (CC0)
©Philip Freeman, some rights reserved (CC0)
©Philip Freeman, some rights reserved (CC0)
©Philip Freeman, some rights reserved (CC0)
©Philip Freeman, some rights reserved (CC0)
©Philip Freeman, some rights reserved (CC0)
©Philip Freeman, some rights reserved (CC0)
©picioarelungi, some rights reserved (CC-BY-NC)
©Great Purple Heron, some rights reserved (CC-BY-NC)
©herty, some rights reserved (CC-BY-NC)
©evaughan55, some rights reserved (CC-BY-NC)
©ejackson46, some rights reserved (CC-BY-NC)
©schober_reanna, some rights reserved (CC-BY-NC)
©valmicmukund, some rights reserved (CC-BY-NC)
©valmicmukund, some rights reserved (CC-BY-NC)
©valmicmukund, some rights reserved (CC-BY-NC)
©valmicmukund, some rights reserved (CC-BY-NC)
©Andrew Sebastian, some rights reserved (CC-BY)
©lululumine, some rights reserved (CC-BY-NC)
©lululumine, some rights reserved (CC-BY-NC)
©victoriabrendel, some rights reserved (CC-BY-NC)
©victoriabrendel, some rights reserved (CC-BY-NC)
©victoriabrendel, some rights reserved (CC-BY-NC)
©victoriabrendel, some rights reserved (CC-BY-NC)
©mari0528, some rights reserved (CC-BY-NC)
©Milo, some rights reserved (CC-BY-NC)
©bio1300echannah, some rights reserved (CC-BY-NC)
©benstar, some rights reserved (CC-BY-NC)
©Karl Feng, some rights reserved (CC-BY-NC)
©Karl Feng, some rights reserved (CC-BY-NC)
©tennesseehills, some rights reserved (CC-BY-NC)
©Lexi Amico, some rights reserved (CC-BY)
©Lexi Amico, some rights reserved (CC-BY)
©Lexi Amico, some rights reserved (CC-BY)
©Lexi Amico, some rights reserved (CC-BY)
©hobofreeman, some rights reserved (CC-BY-NC)
©hobofreeman, some rights reserved (CC-BY-NC)